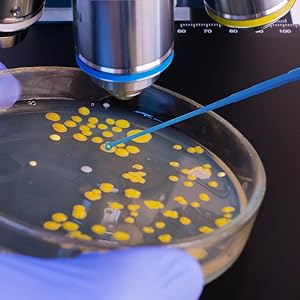

🧬 Elevate your lab game with precision and purity – don’t let contamination hold you back!
These 100pcs 10µL disposable sampling rods by BIOLOGIX feature flexible polystyrene construction with double-ended tips for versatile lab use. Gamma ray sterilization guarantees a contamination-free experience, while ultra-smooth surfaces protect cell integrity. Packaged in resealable bags of 25, they offer convenience and reliability for professional laboratory sampling.

| Manufacturer | BIOLOGIX |
| Part number | PF65-0010 |
| Item Weight | 150 g |
| Product Dimensions | 19.79 x 5.84 x 2.77 cm; 150 g |
| Included Components | Interference loop |
| Batteries Included | No |
| Batteries Required? | No |
| Item Dimensions LxWxH | 19.8 x 5.8 x 2.8 cm |
B**D
Long and useful.
Although, it says for petri dishes, I use them as stir sticks. They are a perfect length for my 750ml thermos. They were sturdy and long enough to do the job well.
TrustPilot
3 周前
1 个月前
1 个月前
3 周前